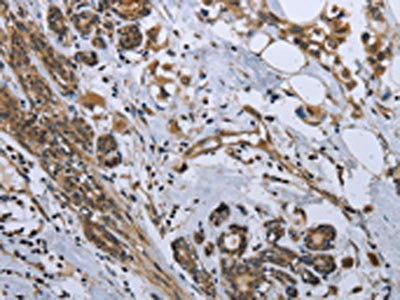

-
中文名稱:GDF3兔多克隆抗體
-
貨號:CSB-PA558316
-
規格:¥1100
-
圖片:
-
The image on the left is immunohistochemistry of paraffin-embedded Human thyroid cancer tissue using CSB-PA558316(GDF3 Antibody) at dilution 1/25, on the right is treated with fusion protein. (Original magnification: ×200)
-
The image on the left is immunohistochemistry of paraffin-embedded Human breast cancer tissue using CSB-PA558316(GDF3 Antibody) at dilution 1/25, on the right is treated with fusion protein. (Original magnification: ×200)
-
Gel: 6%SDS-PAGE, Lysate: 40 μg, Lane: Mouse kidney tissue, Primary antibody: CSB-PA558316(GDF3 Antibody) at dilution 1/250, Secondary antibody: Goat anti rabbit IgG at 1/8000 dilution, Exposure time: 1 minute
-
-
其他:
產品詳情
-
Uniprot No.:
-
基因名:
-
別名:C78318 antibody; ecat9 antibody; GDF 3 antibody; GDF-3 antibody; GDF3 antibody; GDF3_HUMAN antibody; Growth differentiation factor 3 antibody; Growth/differentiation factor 3 antibody; KFS3 antibody; MCOP7 antibody; MCOPCB6 antibody; MGC123990 antibody; MGC123991 antibody; RGD1564178 antibody; Vgr 2 antibody; Vgr2 antibody
-
宿主:Rabbit
-
反應種屬:Human,Mouse
-
免疫原:Fusion protein of Human GDF3
-
免疫原種屬:Homo sapiens (Human)
-
標記方式:Non-conjugated
-
抗體亞型:IgG
-
純化方式:Antigen affinity purification
-
濃度:It differs from different batches. Please contact us to confirm it.
-
保存緩沖液:-20°C, pH7.4 PBS, 0.05% NaN3, 40% Glycerol
-
產品提供形式:Liquid
-
應用范圍:ELISA,WB,IHC
-
推薦稀釋比:
Application Recommended Dilution ELISA 1:1000-1:2000 WB 1:200-1:1000 IHC 1:25-1:100 -
Protocols:
-
儲存條件:Upon receipt, store at -20°C or -80°C. Avoid repeated freeze.
-
貨期:Basically, we can dispatch the products out in 1-3 working days after receiving your orders. Delivery time maybe differs from different purchasing way or location, please kindly consult your local distributors for specific delivery time.
-
用途:For Research Use Only. Not for use in diagnostic or therapeutic procedures.
相關產品
靶點詳情
-
功能:Growth factor involved in early embryonic development and adipose-tissue homeostasis. During embryogenesis controls formation of anterior visceral endoderm and mesoderm and the establishment of anterior-posterior identity through a receptor complex comprising the receptor ACVR1B and the coreceptor TDGF1/Cripto. Regulates adipose-tissue homeostasis and energy balance under nutrient overload in part by signaling through the receptor complex based on ACVR1C and TDGF1/Cripto.
-
基因功能參考文獻:
- the 4 of the 5 variants in [i]GDF3[/i] gene contribute different pathogenicity in congenital scoliosis, which may provide molecular evidence for clinical genetic testing. PMID: 29735971
- OCT4 plays a role as a transcriptional activator for GDF3 transcription in pluripotent human embryonic carcinoma NCCIT cells and contributes to the understanding of the molecular networks of stem cell regulators in germ cell-derived pluripotency and tumorigenesis. PMID: 27803451
- The results expand the spectrum of mutations associated with CHDs and first suggest the potentially disease-related GDF3 gene variant in the pathogenesis of CHDs. PMID: 25372014
- first evidence that NANOG is a transcriptional activator of the expression of the oncogenic growth factor GDF3 in embryonic carcinoma cells PMID: 22963770
- GDF3 expression level was significantly down-regulated in breast cancer tissues compared to the surrounding nontumorous tissues. PMID: 22488170
- the conditioned medium from CHO-GDF3 could reduce PC12 cell growth and induce cell differentiation PMID: 21805089
- Growth differentiation factor 3 is induced by bone morphogenetic protein 6 (BMP-6) and BMP-7 and increases luteinizing hormone receptor messenger RNA expression in human granulosa cells. PMID: 22305102
- Mutation of GDF3 causes ocular and skeletal anomalies. PMID: 19864492
- Present data suggested that GDF3 might play important roles in the central nervous system (CNS), especially in cerebral cortex, hippocampus and cerebellum, and it shed new light on further research of GDF3 in the central nervous system. PMID: 16126341
- GDF3 regulates both of the two major characteristics of embryonic stem cells: the ability to maintain the undifferentiated state and the ability to differentiate into the full spectrum of cell types. PMID: 16339188
- GDF3 regulates adipose-tissue homeostasis and energy balance under nutrient overload in part by signaling through the ALK7 receptor PMID: 18480259
- GDF3 is either a bi-functional TGF-beta ligand, or, more likely, that it is a BMP inhibitor that can artificially activate Nodal signaling under non-physiological conditions. PMID: 18823971
- GDF3 positivity is helpful in the diagnosis of yolk sac tumor PMID: 19396148
顯示更多
收起更多
-
相關疾?。?/div>Klippel-Feil syndrome 3, autosomal dominant (KFS3); Microphthalmia, isolated, with coloboma, 6 (MCOPCB6); Microphthalmia, isolated, 7 (MCOP7)亞細胞定位:Secreted. Cytoplasm.蛋白家族:TGF-beta family數據庫鏈接:
Most popular with customers
-
-
YWHAB Recombinant Monoclonal Antibody
Applications: ELISA, WB, IHC, IF, FC
Species Reactivity: Human, Mouse, Rat
-
Phospho-YAP1 (S127) Recombinant Monoclonal Antibody
Applications: ELISA, WB, IHC
Species Reactivity: Human
-
-
-
-
-